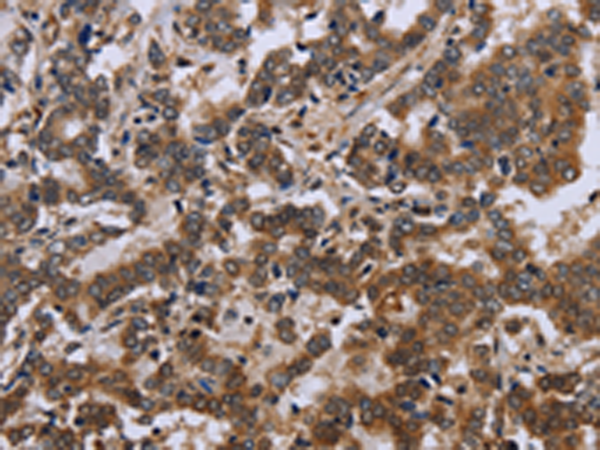

|
Background: |
The protein encoded by this gene binds RNA and is associated with polysomes. The encoded protein may be involved in mRNA trafficking from the nucleus to the cytoplasm. A trinucleotide repeat (CGG) in the 5' UTR is normally found at 6-53 copies, but an expansion to 55-230 repeats is the cause of fragile X syndrome. Expansion of the trinucleotide repeat may also cause one form of premature ovarian failure (POF1). Multiple alternatively spliced transcript variants that encode different protein isoforms and which are located in different cellular locations have been described for this gene. |
|
Applications: |
ELISA, IHC |
|
Name of antibody: |
FMR1 |
|
Immunogen: |
Fusion protein of human FMR1 |
|
Full name: |
fragile X mental retardation 1 |
|
Synonyms: |
POF; FMRP; POF1; FRAXA |
|
SwissProt: |
Q06787 |
|
ELISA Recommended dilution: |
2000-5000 |
|
IHC positive control: |
Human liver cancer |
|
IHC Recommend dilution: |
50-200 |
購物車
幫助
021-54845833/15800441009
